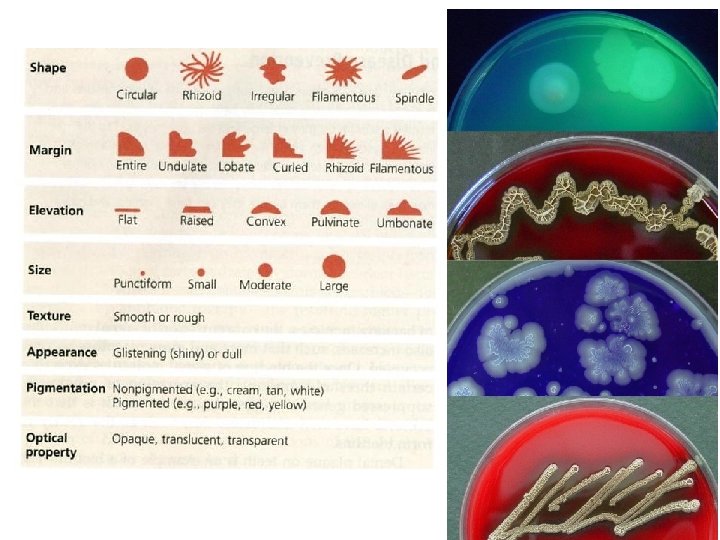
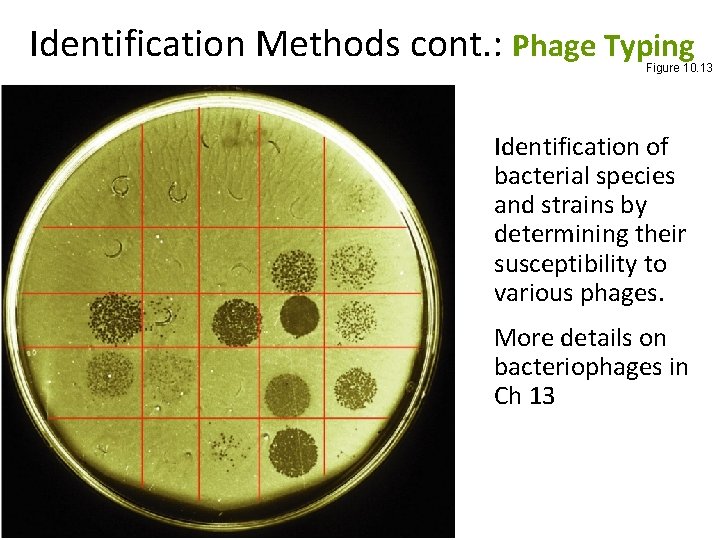
Identification Methods cont. : Phage Typing Figure 10. 13 Identification of bacterial species and Identification Methods cont. : Phage Typing Figure 10. 13 Identification of bacterial species and

Classification of Microorganisms Taxonomy and Phylogeny Taxonmoy science

- Slides: 40
Classification of Microorganisms
Taxonomy and Phylogeny Taxonmoy: science of classifying organisms with goal of showing relationships among organisms. • Taxonomic categories: Taxon / Taxa • Provides universal names for organisms and a means of identifying them. Phylogeny (or systematics): evolutionary history of group of organisms. • Taxonomic hierarchy shows phylogenetic (evolutionary), relationships among organisms. • 1969: Living organisms divided into five kingdoms. • 1978: Two types of prokaryotic cells found. Prokaryotic relationships determined by r. RNA sequencing.
• 1735 • 1857 • 1866 Taxonomy Plant and Animal Kingdoms Bacteria & fungi put in the Plant Kingdom Protista proposed for bacteria, protozoa, algae, & fungi • 1937 "Prokaryote" introduced for cells "without a nucleus" • 1961 Prokaryote defined as cells in which nucleoplasm is not surrounded by a nuclear membrane • 1959 Kingdom Fungi • 1968 Kingdom Prokaryotae proposed • 1978 Two types of prokaryotic cells found
Level Above Kindom: The Three-Domain System Carl Woese 1978 Eubacteria (virtuosos) Archaea (weirdoes) Eukarya (predators and thieves)
The Three-Domain System Figure 10. 1
Table 10. 2
Endosymbiotic Theory Figure 10. 2 Figure 10. 3
Classification: Species Definition • Eukaryotic species: A group of closely related organisms that breed among themselves • Prokaryotic species: A population of cells with similar characteristics (Bergey’s Manual of Systematic Bacteriology is standard reference on bacterial classification). – Clone: Population of cells derived from a single cell – Strain: Genetically different cells within a clone – Closely related strains constitute a bacterial species. • Viral species: Population of viruses with similar characteristics occupying a particular ecological niche. Viruses: not placed in a kingdom – not composed of cells – cannot grow without a host cell.
Scientific Nomenclature Scientific Binomial Source of Genus Name Source of Specific Epithet Klebsiella pneumoniae Honors Edwin Klebs The disease Pfiesteria piscicida Honors Lois Pfiester Disease in fish Salmonella typhimurium Honors Daniel Salmon Stupor (typh-) in mice (muri-) Streptococcus pyogenes Chains of cells (strepto-) Forms pus (pyo-) (-myces) that Saccharomyces cerevisiae Fungus uses sugar (saccharo) Trypanosoma cruzi Makes beer (cerevisiae) Corkscrew-like (trypano-, Honors Oswaldo Cruz borer; soma-, body)
Taxonomic Hierarchy Figure 10. 5
Domain Eukarya • Animalia: Multicellular; no cell walls; chemoheterotrophic • Plantae: Multicellular; cellulose cell walls; usually photoautotrophic • Fungi: Chemoheterotrophic; unicellular or multicellular; cell walls of chitin; develop from spores or hyphal fragments • Protista: A catchall for eukaryotic organisms that do not fit other kingdoms
Fig 10. 8 Identification Methods • Morphological characteristics: Useful for identifying eukaryotes § Differential staining: Gram staining, acid-fast staining § Biochemical tests: Determines presence of bacterial enzymes
Bergey’s Manual: Classifying and Identifying Prokaryotes Bergey’s Manual of Determinative Bacteriology: Is standard reference for laboratory identification of bacteria. Bergey’s Manual of Systematic Bacteriology Provides phylogenetic information on bacteria and archaea Morphology, differential staining, biochemical tests to test for presence of various enzymes. Based on r. RNA sequencing
The first edition of Bergey's Manual of Determinative Bacteriology was initiated by action of the Society of American Bacteriologists (now called the American Society for Microbiology) by appointment of an Editorial Board consisting of David H. Bergey as Chairman, published the Journal of Bacteriology in 1923. The Board, with some changes in membership and Dr. David Bergey as Chairman, published a second edition of the Manual in 1925 and a third edition in 1930. They have published, successively, the fourth, fifth, sixth, seventh, and eighth editions of the Manual (dated 1934, 1939, 1948, 1957, and 1974, respectively. 1981 The Trust is presently publishing the first edition of Bergey's Manual® of Systematic Bacteriology, which has a much broader scope than the previous publications and is intended to act as the amplified source for revision of the determinative Manual.
Bergey's Manual of Determinative Bacteriology 9 th Edition Edited by John G. Holt Copyright 1994 the Determinative manual serving as a reference to aid in the identification of unknown bacteria. dividing the bacteria into easily recognized phenotypic groups. Volume 1 (1984) Gram-negative Bacteria of general, medical, or industrial importance Volume 2 (1986) Gram-positive Bacteria other than Actinomycetes Volume 3 (1989) Archaeobacteria, Cyanobacteria, and remaining Gram-negative Bacteria Volume 4 (1989) Actinomycetes The manual was published subsequent to the Bergey's Manual of Determinative Bacteriology, though the latter is still published as a guide for identifying unknown bacteriain 1923 by David Hendricks Bergey,
DETERMINATIVE vs SYSTEMATIC BERGEY’S MANUAL OF DETERMINATIVE BACTERIOLOGY BERGEY’S MANUAL OF SYSTEMATIC BACTERIOLOGY Provides identification schemes for identifying bacteria and archaea Provides phylogenetic information on bacteria and archaea Based on Morphology, differential staining, biochemical tests Based on r. RNA sequencing Standard reference for laboratory identification of bacteria. Standard reference on bacterial classification The organization of Bergey's Manual of Systematic Bacteriology makes it impractical for helping place unknown bacteria into major taxa, BUT it contains far more detail on the families, genera, and species and is far more up to date than the Determinative manual.
Bacteria grow on solid media as colonies. A colony is defined as a visible mass of microorganisms all originating from a single mother cell, therefore a colony constitutes a clone of bacteria all genetically alike. In the identification of bacteria and fungi much weight is placed on how the organism grows in or on media. This exercise will help you identify the cultural characteristics of a bacterium on an agar plate---called colony morphology. WHOLE SHAPE OF COLONY. Varies from round to irregular to filamentous and rhizoid SIZE OF COLONY (measure with a millimeter rule). Can vary from large colonies to tiny colonies less than 1 mm = punctiform (pin-point). EDGE/MARGIN OF COLONY: magnified edge shape (use a dissecting microscope) CHROMOGENESIS (color of colonies, pigmentation OPACITY OF COLONY: Is the colony transparent (clear), opaque (not transparent or clear), translucent (almost clear, but distorted vision–like looking through frosted glass), iridescent (changing colors in reflected light)? ELEVATION OF COLONY: How much does the colony rise above the agar (turn the plate on end to determine height)? SURFACE OF COLONY: smooth, glistening, rough, dull (opposite of glistening), rugose (wrinkled) CONSISTENCY or TEXTURE: butyrous (buttery), viscid (sticks to loop, hard to get off), brittle/friable (dry, breaks apart), mucoid (sticky, mucus-like) *Specific biochemical requirements
Motility, special charecters
Identification Methods cont. : Serology • Involves reactions of microorganisms with specific antibodies: Combine known anti-serum with unknown bacterium • Useful in determining the identity of strains and species, as well as relationships among organisms. § Examples: § Slide agglutination § ELISA (see lab) § Western blot (no details) Fig 10. 10: Slide Agglutination
Identification Methods cont. : Phage Typing Figure 10. 13 Identification of bacterial species and strains by determining their susceptibility to various phages. More details on bacteriophages in Ch 13
Identification Methods cont. : Genetics • DNA fingerprinting: Number and sizes of DNA fragments (fingerprints) produced by RE digests are used to determine genetic similarities. • Ribotyping: r. RNA sequencing • Polymerase chain reaction (PCR) can be used to amplify a small amount of microbial DNA in a sample. The presence or identification of an organism is indicated by amplified DNA. (see lab) Fig 10. 14: Electrophoresis of RE digest of plasmid DNA
Identification Methods cont. : Nucleic Acid Hybridization Single strands of DNA or RNA, from related organisms will hydrogen-bond to form a double-stranded molecule; this bonding is called nucleic acid hybridization. Examples of Applications: • Southern blotting, • DNA chips, and • FISH Figs. 10. 17 and 10. 18 Fig 10. 15
Putting Identification/Classification Methods Together • Dichotomous keys are widely used for identification of organisms. They are based on successive questions that each have two possible answers • Cladograms are maps that show phylogenentic (evolutionary) relationship. Method used to establish cladogram for microorganisms? Animation: Dichotomous Keys (The Microbiology Place)
Microbiology in the News (p. 294): Mass Death of Marine Mammals Dichotomous Key
Ch 10 Classification of Microorganisms